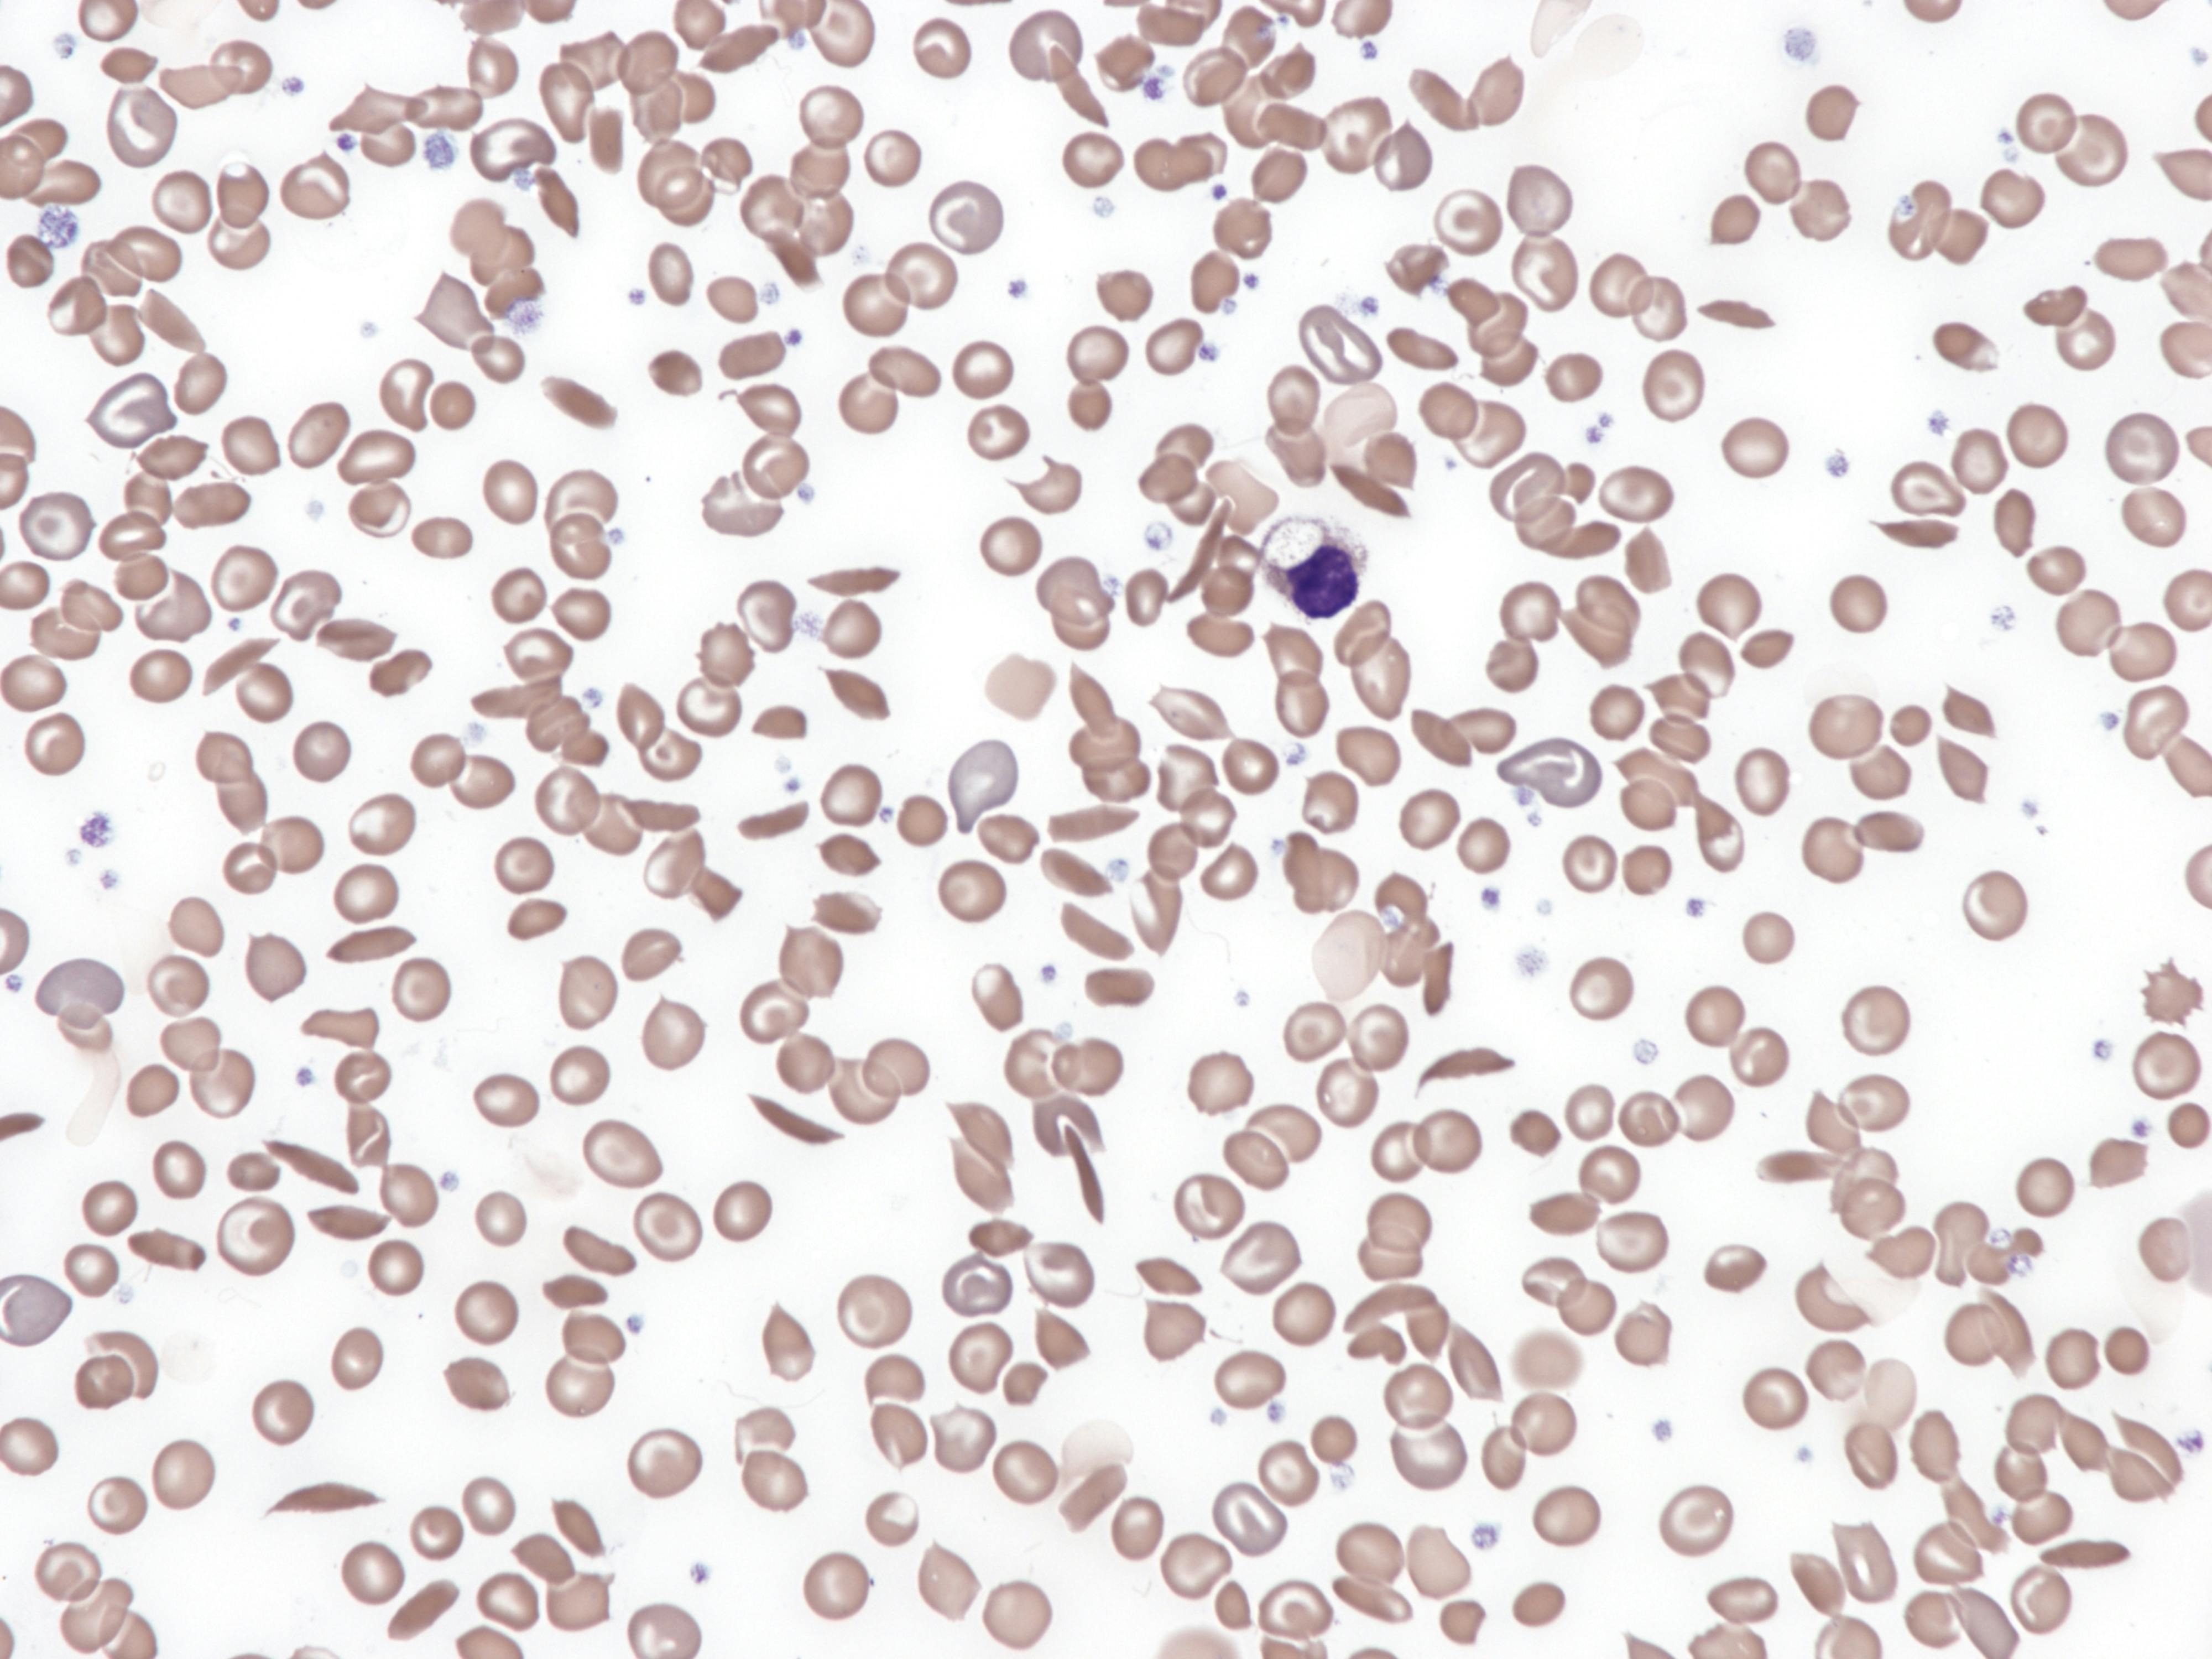
6696cc579ff2521da2b8c6a2 Dreamstime Xxl 305554952

While distress is well-documented in patients with sickle cell disease, sources of distress and how patients manage distress have not been well explored.
“Our study found that the most profound source of distress for patient with sickle cell disease in a home visit program was anticipating and going to acute care centers to manage their acute pain,” said senior study author Maryanna Klatt, PhD, director of the Center for Integrative Health at The Ohio State University Wexner Medical Center.
Study findings are published in the journal Qualitative Research in Health.
These findings bolster researchers’ earlier perspective published in the New England Journal of Medicine that cited a need for a biopsychosocial model to treat chronic pain in sickle cell disease.
Researchers recruited 11 patients with sickle cell from a home visit program at Ohio State Wexner Medical Center between February and July 2021. They wanted to identify sources of distress for persons with sickle cell.
A researcher conducted one-on-one semi-structured interviews with study participants. The research team coded and analyzed all interview transcripts.
Participants said the most profound source of distress was clinical encounters in the emergency department and intermediate care center to manage acute pain flares.
Key findings
• “Pain performativity” is a strategy some patients use to try to show providers their pain.
• Researchers should consider how clinical settings and practices foster distress.
• Listening to patients may help clinicians to reduce distress.
“We found that there is often a performative element for persons with sickle cell in emergency and intermediate care center settings. They feel they have to present in a certain way for providers to see their pain as credible and treat it promptly. Yet often, patients are simply incapable of performing their pain, or ‘crying on cue,’ as one participant put it,” said study first author Janet Childerhose, PhD, a research assistant professor in the Department of Internal Medicine at the Ohio State’s College of Medicine.
“Our analysis also found stigma and racism surround the care of this neglected disease. Participants lack any sense of control over their pain management plan,” said Klatt, who also is a professor in the Department of Family and Community Medicine. “Researchers may wish to consider how these settings could better address patient distress, and providers may wish to adopt participant recommendations to reduce distress associated with seeking pain treatment in acute care settings.”